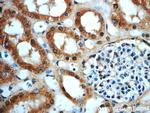
ERBB2IP Antibody in Immunohistochemistry (Paraffin) (IHC (P))

Search
Proteintech
ERBB2IP Polyclonal Antibody
{{$productOrderCtrl.translations['antibody.pdp.commerceCard.promotion.promotions']}}
{{$productOrderCtrl.translations['antibody.pdp.commerceCard.promotion.viewpromo']}}
{{$productOrderCtrl.translations['antibody.pdp.commerceCard.promotion.promocode']}}: {{promo.promoCode}} {{promo.promoTitle}} {{promo.promoDescription}}. {{$productOrderCtrl.translations['antibody.pdp.commerceCard.promotion.learnmore']}}
产品信息
22438-1-AP
种属反应
已发表种属
宿主/亚型
分类
类型
抗原
偶联物
形式
浓度
规格
纯化类型
保存液
内含物
保存条件
运输条件
产品详细信息
Immunogen sequence: AFECDEDKD EREAPPREGN LKRYPTPYPD ELKNMVKTVQ TIVHRLKDEE TNEDSGRDLK PHEDQQDINK DVGVKTSEST TTVKSKVGER EKYMIGNSVQ KISEPEAEIS PGSLPVTANM KASENLKHIV NHDDVFEESE ELSSDEEMKM AEMRPPLIET SINQPKVVAL SNNKKDDTKE TDSLSDEVTH NSNQNNSNCS SPSRMSDSVS LNTDSSQDTS LCSPVKQTHI DINSKIRQED ENFNSLLQNG DILNSSTEEK FKAHDKKDFN LPEYDLNVEE RLVLIEKSVD STATADDTHK LDHINMNLNK LITNDTFQPE IMERSKTQDI VLGTSFLSIN SKEETEHLEN G (461-810 aa encoded by BC115012)
靶标信息
The protein encoded by this gene is a component of the exocyst complex, a multiple protein complex essential for targeting exocytic vesicles to specific docking sites on the plasma membrane. Though best characterized in yeast, the component proteins and functions of exocyst complex have been demonstrated to be highly conserved in higher eukaryotes. At least eight components of the exocyst complex, including this protein, are found to interact with the actin cytoskeletal remodeling and vesicle transport machinery. The complex is also essential for the biogenesis of epithelial cell surface polarity. Alternate transcriptional splice variants, encoding different isoforms, have been characterized.
仅用于科研。不用于诊断过程。未经明确授权不得转售。
生物信息学
蛋白别名: basolateral protein; Densin-180-like protein; epididymis secretory protein Li 78; Erbb2-interacting protein; Erbin; Protein LAP2; unnamed protein product
基因别名: ERBB2IP; ERBIN; HEL-S-78; KIAA1225; LAP2
UniProt ID: (Human) Q96RT1
Entrez Gene ID: (Human) 55914